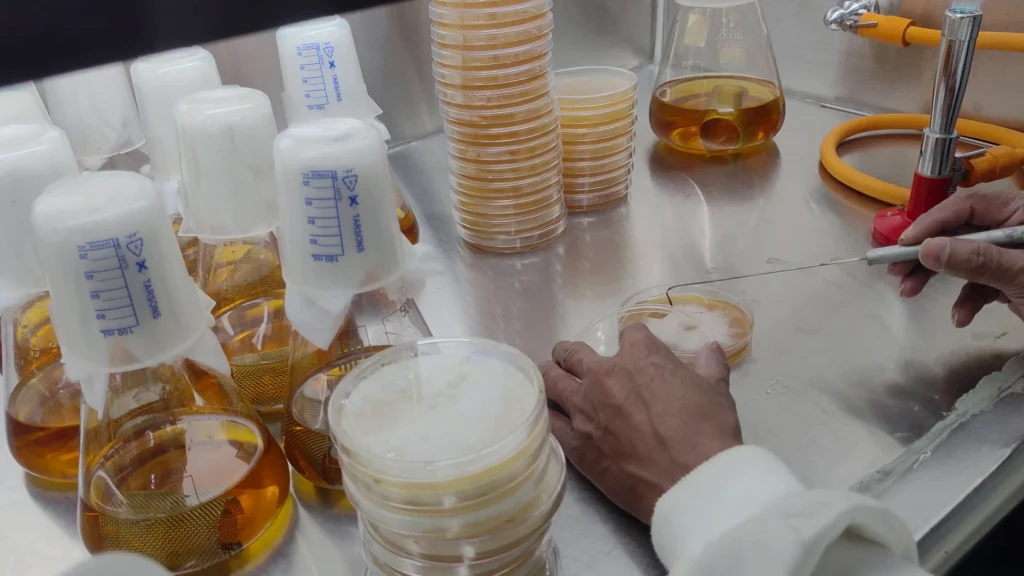
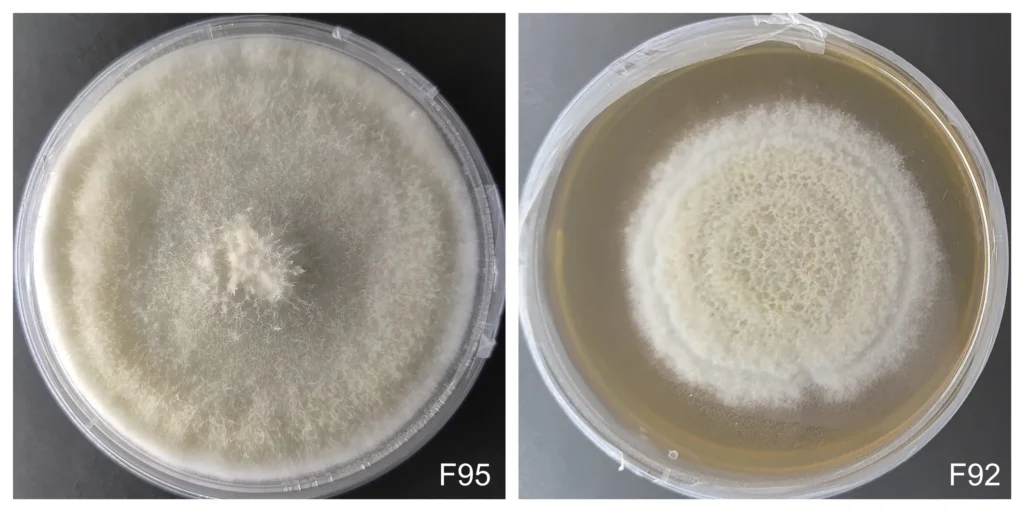
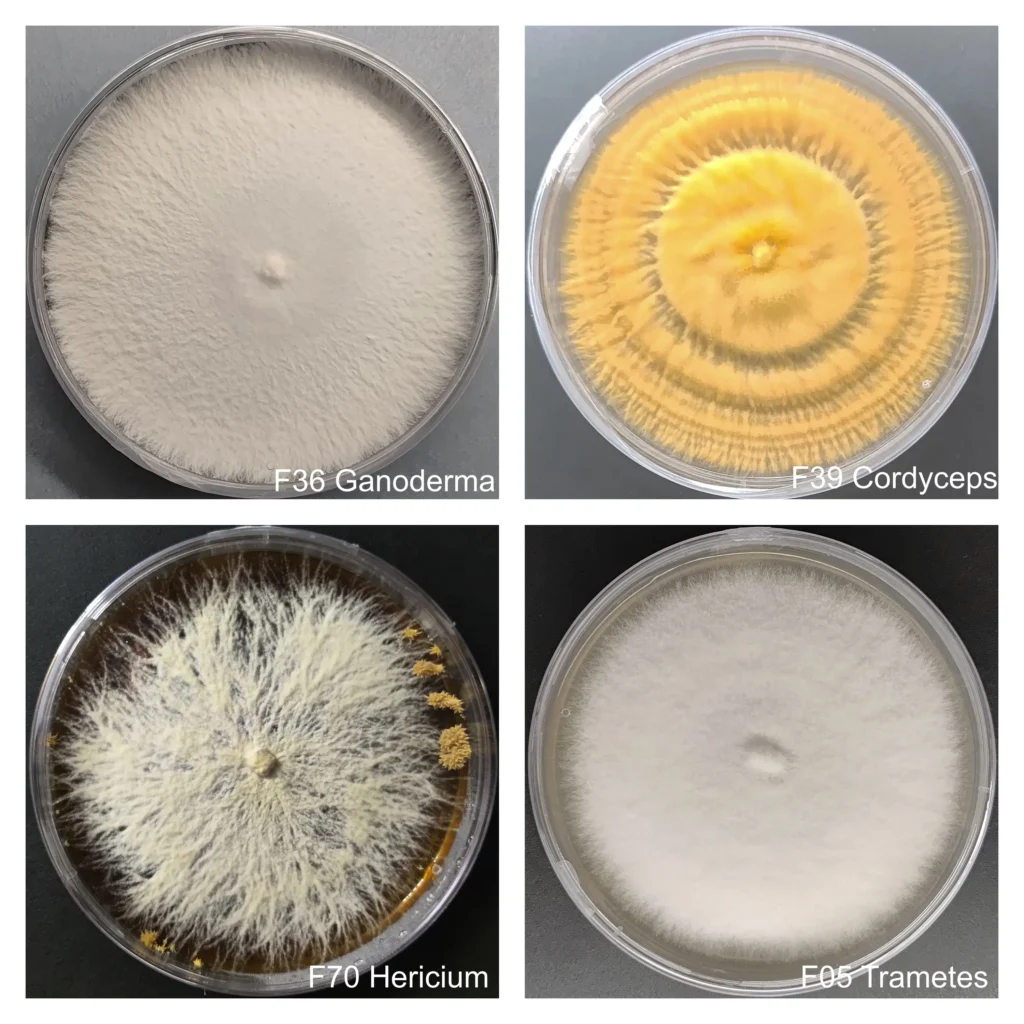
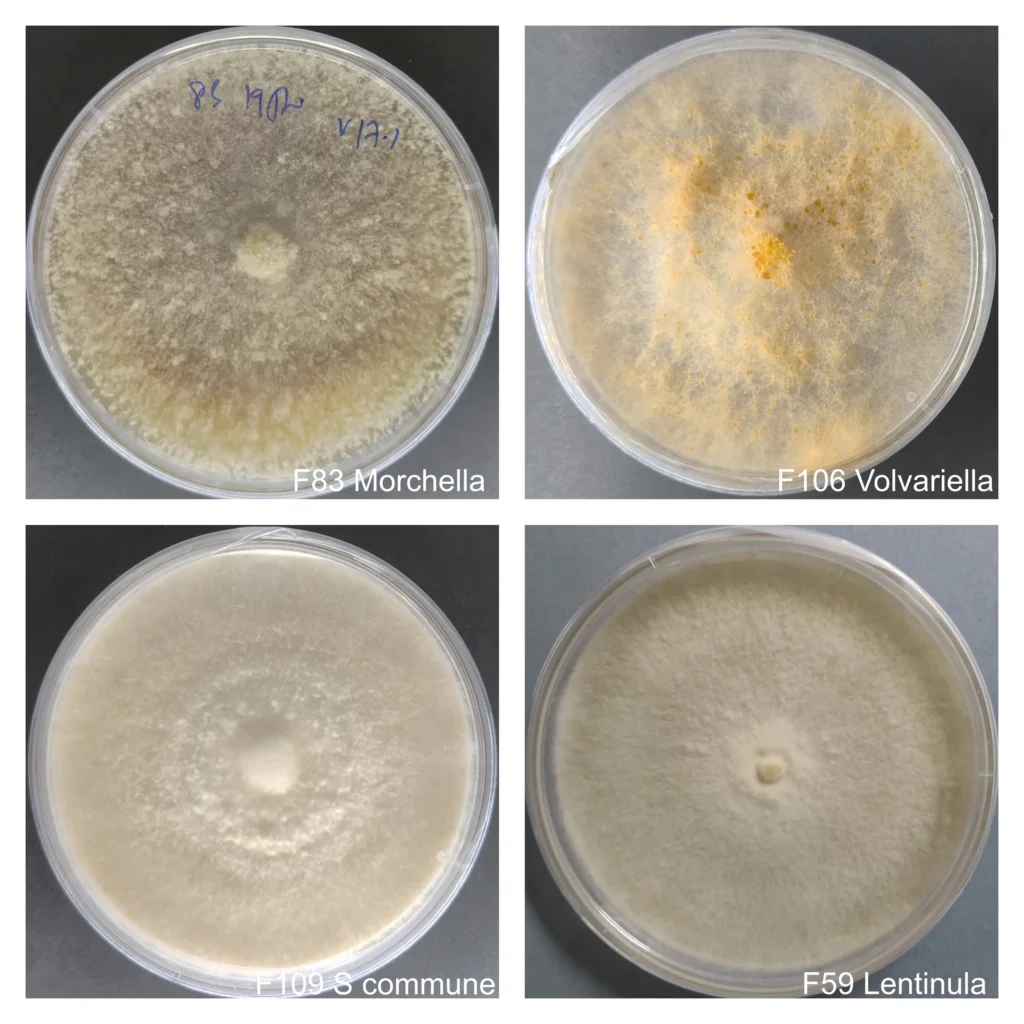
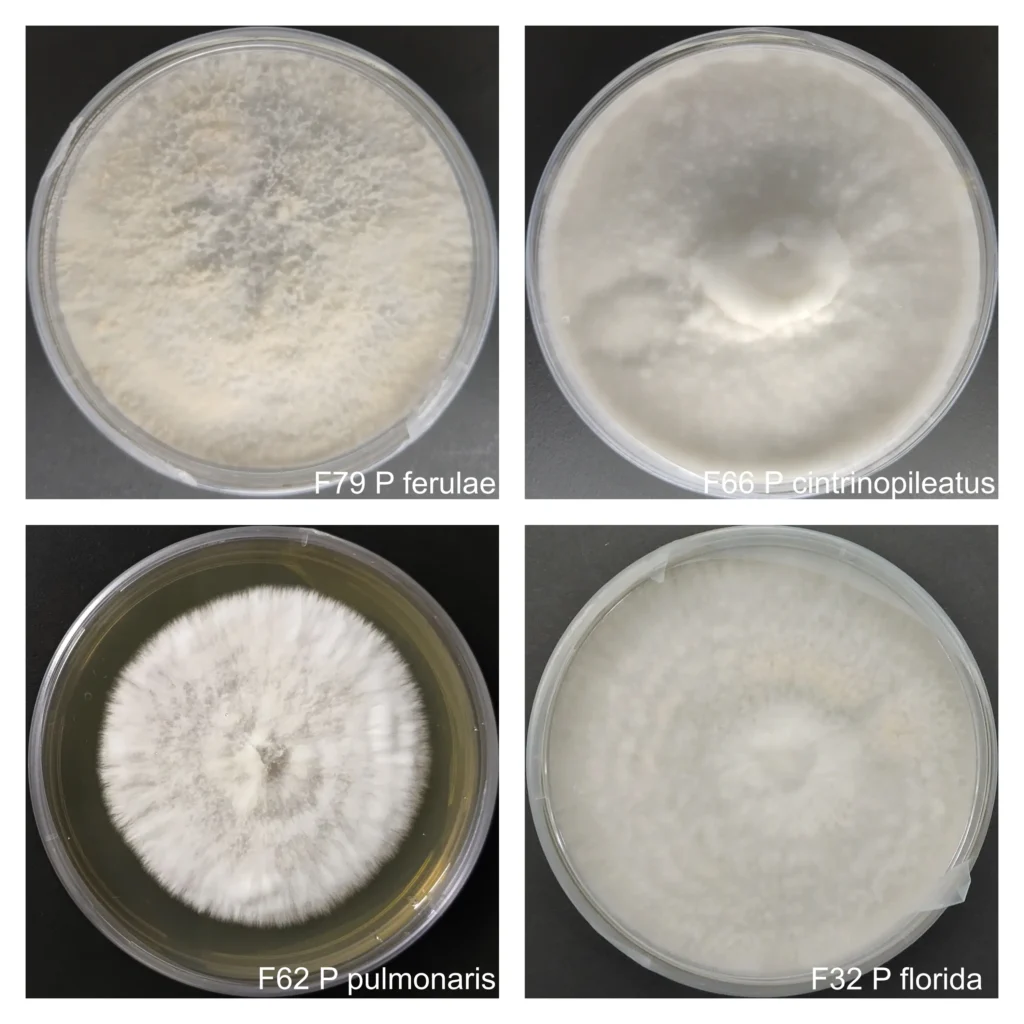

Advancing Commercial Mushroom Cultivation Technologies
Research, Training and Innovative Solutions for Commercial and Sustainable Mushroom Cultivation Technologies including Cordyceps, Shiitake, Enoki, Lion’s mane, Ganoderma, Turkey tail, Oyster and other mushrooms.

India’s Largest Mushroom Culture Bank
Agripie houses India’s largest Mushroom Culture Bank with 50+ species broadly categorized into –
- Medicinal mushrooms
- Pleurotus or Oyster mushrooms
- Specialty & Gourmet mushrooms
- Industrial mushrooms
Key Features of Our Mushroom Cultures
- High Yield commercial strains
- F2/F3 culture plates prepared from cryopreserved stocks
- Free from contaminants
- Cultured on antibiotic free media
- Visibly verifiable colony morphology
Industrial mushrooms have gained significant attention in recent decades due to their roles in bioremediation, plastic degradation, vegan leather, and biomaterial production.
Shop Best Cordyceps Mushrooms

Triple stage drying of Cordyceps mushroom

High Cordycepin and Adenosine content as harvested at day

Cordyceps grown on Rice and all VEG media

Available as Cordyceps mushroom, Powder and Capsules

Most effective Cordyceps mushroom

Cordyceps Cultivated and Dried following Food Safety Protocols
Cordyceps Training and Support
Agripie offers hands-on training and on-site training with expert consultancy for commercial cultivation of Cordyceps militaris mushroom. It is the most sophisticated training program covering up every aspects of a successful commercial Cordyceps production unit.

Design of culture vessel yielding 10 grams dried Cordyceps per jar
Design and Optimization of Time-dependent Incubation Conditions for Maximum Yield